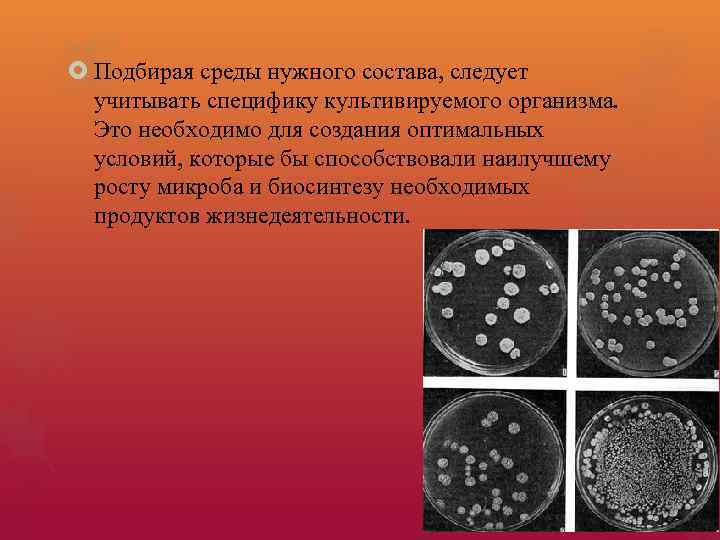
Подбирая среды нужного состава, следует учитывать специфику культивируемого организма. Это необходимо для создания

Способы получения антибиотиков.pptx
- Количество слайдов: 21

Способы получения антибиотиков

В настоящее время различают три способа получения антибиотиков: биологический, метод получения полусинтетических препаратов и синтез химических соединений — аналогов природных антибиотиков

Биологический синтез Полностью химическая структура установлена одной трети известных антибиотиков и только половина из них может быть получена химическим синтезом. Поэтому микробиологический синтез получения антибиотических средств очень актуален.

Синтез микроорганизмами антибиотиков – одна из форм проявления антагонизма; связан с определенным характером обмена веществ, возникшим и закрепленным ходе его эволюции, то есть это наследственная особенность, выражающаяся в образовании одного и более определенных, строго специфичных для каждого вида антибиотических веществ.

Промышленное получение антибиотиков, как правило, осуществляется путем биосинтеза и включает следующие стадии: • выбор высокопроизводительных штаммов продуцента (до 45 тыс. ЕД/мл) • выбор питательной среды; • процесс биосинтеза; • выделение антибиотика из культуральной жидкости; • очистка антибиотика.

Выбор высокопроизводительных штаммов продуцента. Природные штаммы в большинстве своем малоактивны и не могут использоваться для промышленных целей. Поэтому после отбора наиболее активного природного штамма для повышения его продуктивности применяют различные мутагены, вызывающие стойкие наследственные изменения. Эффективными мутагенами являются мутагены физической природы — ультрафиолетовое и рентгеновское излучение, быстрые нейтроны или химические вещества. Использование мутагенов позволяет не только повысить продуктивность природного штамма, но и получать штаммы с новыми неизвестными для природного микроорганизма свойствами.

Подбор рационального состава питательных сред. Понятие «среда для культивирования» включает не только определенный качественный и количественный состав компонентов или отдельных элементов, необходимых для конструктивного и энергетического омена организма (источники азота, углерода, фосфора, источники ряда микроэлементов, витамины и ростовые вещества), но также и физико-химические и физические факторы (активная кислотность, окислительно-восстановительный потенциал, температура, аэрация и др. ). Все эти факторы взаимосвязаны и играют существенную роль при развитии микроорганизмов
Подбирая среды нужного состава, следует учитывать специфику культивируемого организма. Это необходимо для создания оптимальных условий, которые бы способствовали наилучшему росту микроба и биосинтезу необходимых продуктов жизнедеятельности.

Например, если организм не может синтезировать некоторые существенные для него жизнедеятельности соединения (как например, аминокислоты или витамины) из простых веществ субстрата, то для его развития следует в состав ввести готовые аминокислоты или витамины. К таким «требовательным» организмам относятся некоторые виды бактерий (молочнокислые и др. ).

Методы культивирования продуцентов антибиотиков В современных условиях наиболее перспективным методом выращивания микроорганизмов — продуцентов антибиотиков или других биологически активных соединений признан метод глубинного культивирования. Метод состоит в том, что микроорганизм развивается в толще жидкой питательной среды, через которую непрерывно пропускается стерильный воздух, и среда перемешивается.

В основе этого метода лежит то, что развитие микроорганизма происходит в условиях непрерывного протока питательной среды, что позволяет поддерживать развитие микроорганизма на определенной стадии его роста. Стадия развития микроорганизма определяется исходя из наиболее выгодного для максимального биосинтеза антибиотика или другого биологически активного соединения.

Еще один метод культивирования микроорганизмов – поверхностное культивирование. Метод поверхностного культивирования на различных агаризованных средах широко применяется в лабораторной практике и в некоторых промышленных процессах, в частности для сохранения коллекционных культур, для изучения физиологических и биохимических свойств микроорганизмов, для аналитических целей. В промышленном масштабе этот метод нашел применение при получении спорового материала для производства органических кислот с помощью плесневых грибов рода Aspergillus.

При поверхностном методе культуру микроорганизма-продуцента выращивают на поверхности тонкого слоя жидкой или твердой среда. Жидкие питательные среда используют в основном при производстве органических кислот (лимонной, итаконовой), твердые - при производстве комплексов на основе крахмального и целлюлозу содержащего сырья

Методы выделения антибиотиков из культуральной жидкости весьма разнообразны и определяются химической природой антибиотика. В основном используют следующие методы:

1. Высев почвенной взвеси в воде на поверхность агаровой пластинки Определенная навеска почвы, тщательно растертая в ступке с небольшим объемом воды, количественно переносится в колбу со стерильной водой. Содержимое колбы встряхивается в течение 5 мни, а затем из водной суспензии делается ряд последовательных разведений, которые высеваются на соответствующую авизированную среду. Для получения в дальнейшем чистых культур отдельные колонии после инкубация в термостате при нужной температуре пересеваются в пробирки со скошенным питательным агаром. Каждая чистая культура микроорганизма пересевается на различные по составу среды и после достаточно хорошего развития проверяются ее антибиотические свойства.

2. Высев почвы на питательный агар, предварительно засеянный тест-организмом Поверхность питательного агара засевается тест культурой необходимого организма, после чего на агаровую пластинку раскладывают небольшие, не более просяного зерна, комочки почвы или же почву наносят в виде пыли, распределяя ее по всей поверхности пластинки. Затем чашки помещают в термостат и через определенный промежуток времени (24— 48 ч, а иногда и более) просматривают кусочки почвы или отдельные ее участки, вокруг которых образовались зоны задержки роста тест-организма. Из этих участков выделяют чистые культуры организмов и подвергают их дальнейшему изучению.

3. Метод обогащения почвы Почву, из которой предполагают выделить антагонистов, обогащают организмами тех видов, по отношению к которым хотят получить антагонист. С этой целью к образцам почвы, помешенным в стеклянные сосуды, систематически добавляют отмытую суспензию нужных микроорганизмов. Затем через определенные промежутки времени такая почва высевается в виде отдельных комочков на агаровые пластинки в чашках Петри, предварительно засеянные тем же самым организмом, который использовался для обогащения почвы.

Очистка антибиотика производится хроматографическими методами (хроматография на оксиде алюминия, целлюлозе, ионитах) или противоточной экстракцией. Очищенные антибиотики подвергают лиофильной сушке.

Метод получения полусинтетических препаратов Их готовят комбинированным способом: методом биологического синтеза получают основное ядро молекулы нативного антибиотика, а методом химического синтеза, путем частичного изменения химической структуры — полусинтетические препараты.

Синтез химических соединений — аналогов природных антибиотиков. Изучение химической структуры антибиотиков дало возможность получать их методом химического синтеза. Одним из первых антибиотиков, полученных таким методом, был левомицетин.

Большие успехи в развитии, химии привели к созданию антибиотиков с направленно измененными свойствами, обладающих пролонгированным действием, активных в отношении устойчивых к пенициллину стафилококков. К пролонгированным препаратам относятся экмоновоциллин (Ecmonovocillinum), бициллин 1, 3, 5.
Способы получения антибиотиков.pptx